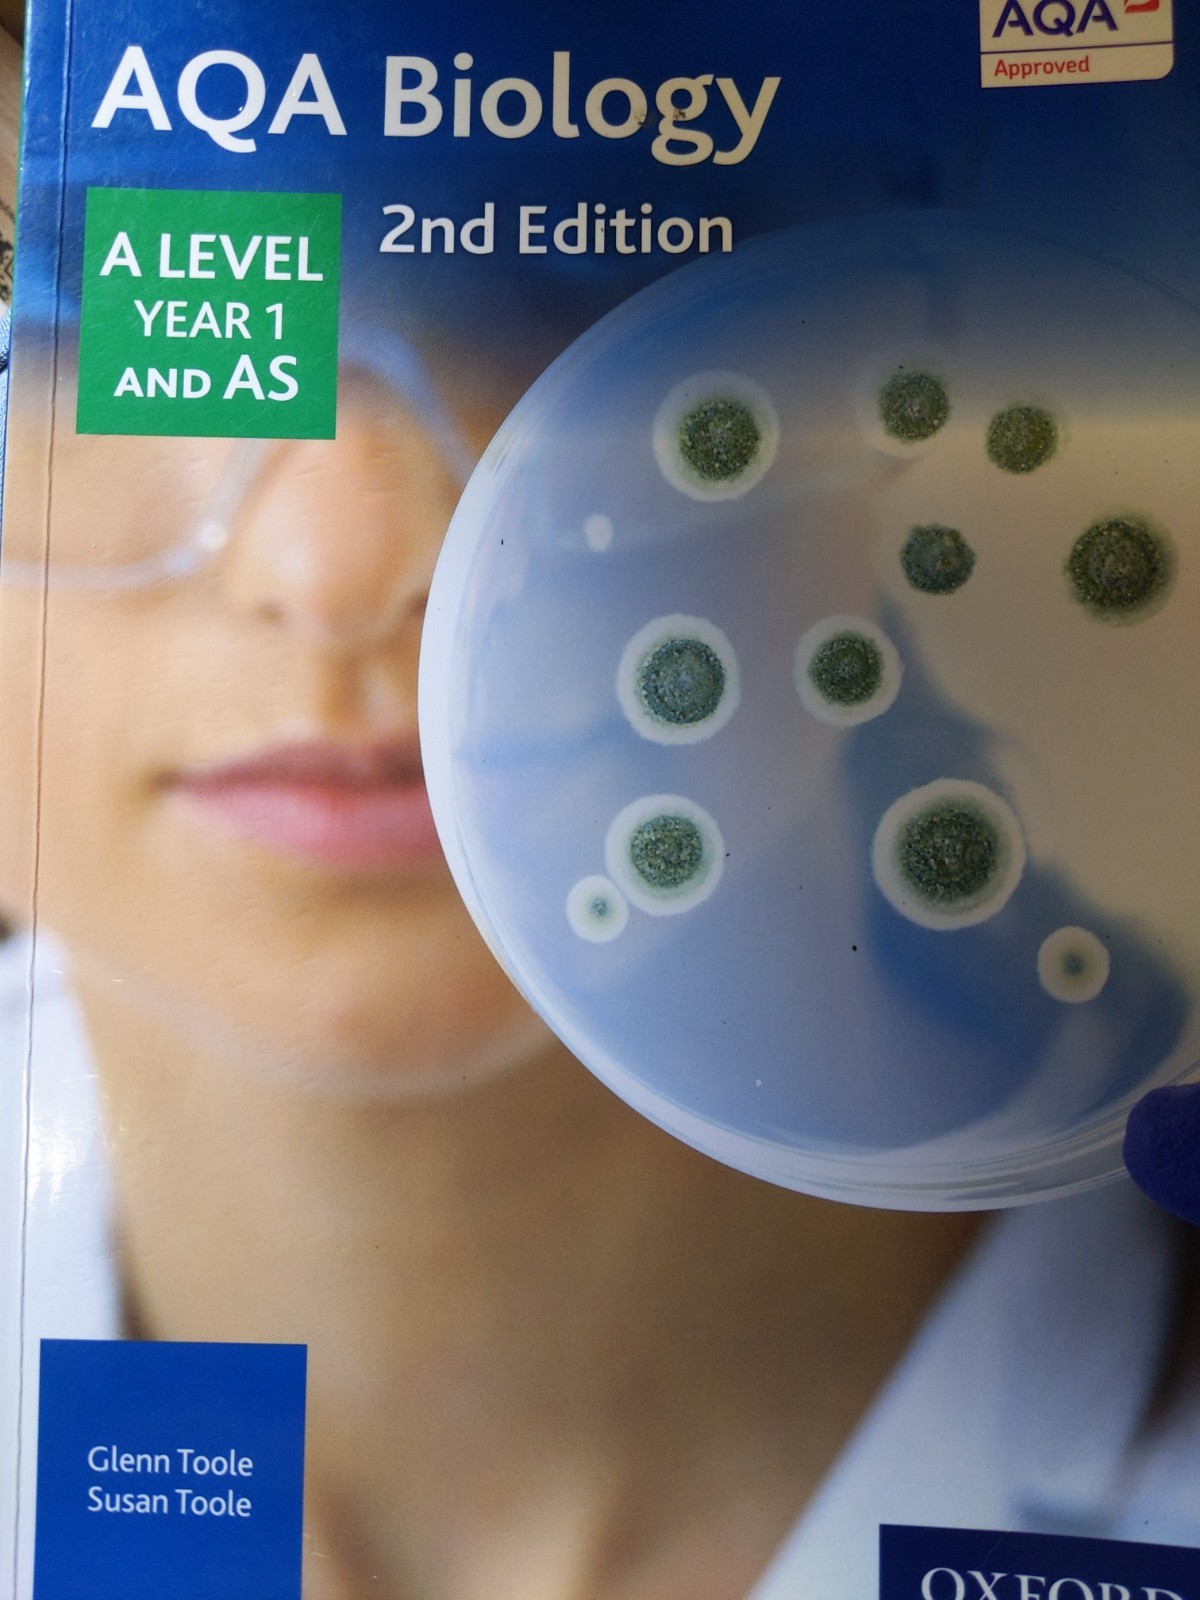

AQA Biology A Level Year 1 Student Book by Glenn Toole, Susan Toole (Paperback,
GBP 10.00GBP 10.00
Sep 07, 05:50Sep 07, 05:50
Picture 1 of 1

Gallery
Picture 1 of 1
Have one to sell?
AQA Biology A Level Year 1 Student Book by Glenn Toole, Susan Toole (Paperback,
GBP 10.00
ApproximatelyS$ 17.31
Condition:
“No highlights. Minor creases”
Good
A book that has been read but is in good condition. Very minimal damage to the cover including scuff marks, but no holes or tears. The dust jacket for hard covers may not be included. Binding has minimal wear. The majority of pages are undamaged with minimal creasing or tearing, minimal pencil underlining of text, no highlighting of text, no writing in margins. No missing pages.
Oops! Looks like we're having trouble connecting to our server.
Refresh your browser window to try again.
Shipping:
GBP 21.59 (approx S$ 37.38) International Priority Shipping to United States via eBay's Global Shipping Program.
Located in: London, United Kingdom
Import charges:
Free amount confirmed at checkout
Delivery:
Estimated between Fri, 10 Oct and Tue, 21 Oct to 94104
Includes international tracking
Returns:
No returns accepted.
Coverage:
Read item description or contact seller for details. See all detailsSee all details on coverage
(Not eligible for eBay purchase protection programmes)
Seller assumes all responsibility for this listing.
eBay item number:157233233534
Item specifics
- Condition
- Good
- Seller Notes
- “No highlights. Minor creases”
- Country/Region of Manufacture
- United Kingdom
- ISBN
- 9780198351764
Item description from the seller
Seller feedback (1,620)
This item (1)
All items (1,620)
- Automatische feedback van eBay- Feedback left by buyer.Past monthBestelling voltooid - getrackt en op tijd
- Automatische feedback van eBay- Feedback left by buyer.Past monthBestelling voltooid - getrackt en op tijd
- Automatische feedback van eBay- Feedback left by buyer.Past monthBestelling voltooid - getrackt en op tijd